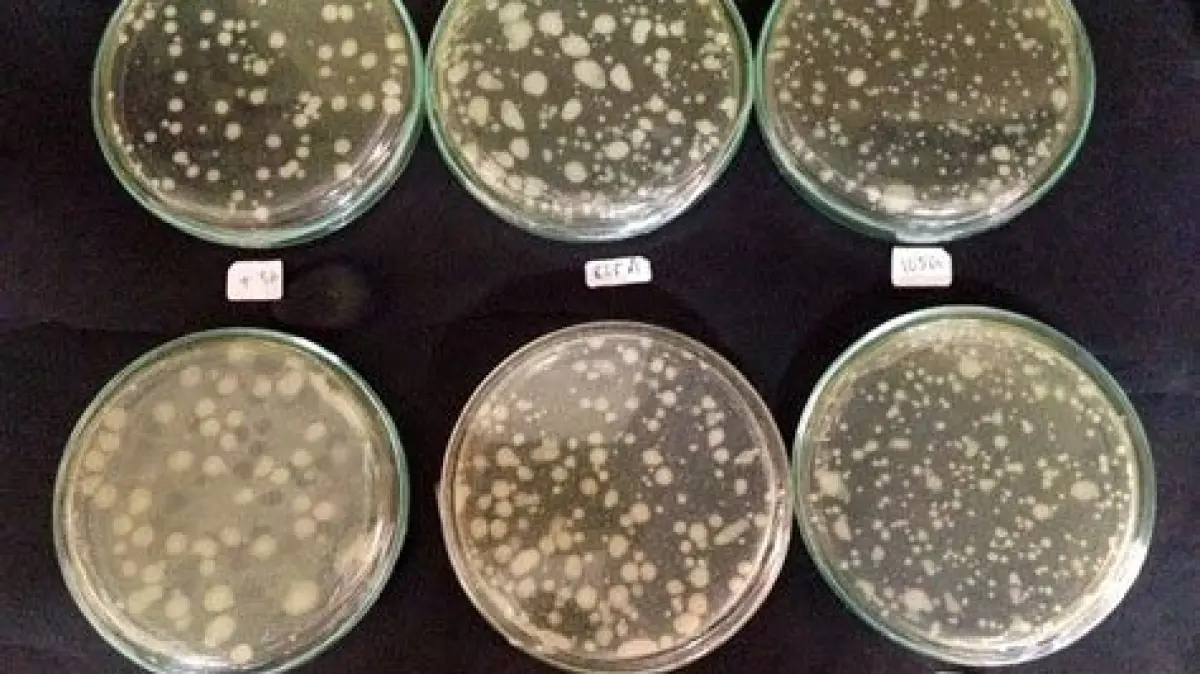

Dominasi Tersembunyi: Siapa Penguasa Populasi di Bumi Sebenarnya?
Ketika kita berbicara tentang penguasa planet ini, seringkali yang terlintas adalah manusia. Namun, jika tolok ukurnya adalah jumlah individu, maka ada dua kelompok makhluk hidup yang jauh meninggalkan kita: semut dan bakteri. Mari kita telaah mengapa mereka begitu sukses dalam mendominasi populasi bumi.

Semut: Tentara Kecil dengan Koloni Raksasa
Semut adalah serangga sosial yang hidup dalam koloni terorganisir dengan sistem kasta yang kompleks. Diperkirakan ada sekitar 20 kuadriliun (20.000.000.000.000.000) semut di seluruh dunia. Mengapa mereka begitu banyak?
Kunci Sukses Semut:
- Organisasi Sosial: Pembagian kerja yang jelas (ratu, pekerja, tentara) meningkatkan efisiensi koloni.
- Adaptasi: Semut mampu beradaptasi dengan berbagai lingkungan, dari hutan hujan hingga gurun.
- Reproduksi: Ratu semut dapat menghasilkan jutaan telur sepanjang hidupnya.
- Pertahanan: Koloni semut memiliki sistem pertahanan yang kuat, melindungi diri dari predator.
Semut memainkan peran penting dalam ekosistem, seperti aerasi tanah, penyebaran biji, dan pengendalian hama. Namun, beberapa spesies semut juga dapat menjadi hama pertanian yang merugikan.
Bakteri: Sang Mikroskopis yang Maha Hadir
Bakteri adalah mikroorganisme uniseluler yang ada di mana-mana: di tanah, air, udara, bahkan di dalam tubuh kita. Jumlah bakteri di bumi diperkirakan mencapai 5 x 1030 (5 noniliun!). Angka yang fantastis, bukan?

Rahasia Populasi Bakteri yang Melimpah:
- Reproduksi Cepat: Bakteri dapat berkembang biak dengan sangat cepat melalui pembelahan biner. Dalam kondisi ideal, satu bakteri dapat menghasilkan jutaan keturunan dalam beberapa jam.
- Adaptasi Ekstrem: Bakteri mampu hidup di lingkungan yang ekstrem, seperti sumber air panas, danau garam, dan bahkan di kedalaman laut.
- Metabolisme Fleksibel: Bakteri memiliki beragam metabolisme, memungkinkan mereka untuk memanfaatkan berbagai sumber energi dan nutrisi.
- Peran Vital: Bakteri memainkan peran kunci dalam siklus nutrisi, dekomposisi materi organik, dan bahkan dalam kesehatan manusia (bakteri baik di usus).
Penting diperhatikan: Tidak semua bakteri berbahaya. Banyak bakteri yang menguntungkan dan penting untuk kehidupan. Namun, beberapa bakteri patogen dapat menyebabkan penyakit.

Mengapa Kita Harus Peduli dengan Populasi Semut dan Bakteri?
Memahami populasi dan peran semut serta bakteri sangat penting karena beberapa alasan:
- Keseimbangan Ekosistem: Perubahan populasi mereka dapat mempengaruhi ekosistem secara keseluruhan.
- Kesehatan Manusia: Interaksi kita dengan bakteri (baik dan buruk) berdampak langsung pada kesehatan.
- Pertanian: Pengendalian hama semut dan pemanfaatan bakteri menguntungkan dapat meningkatkan hasil panen.
Jadi, Siapakah yang Sebenarnya Lebih Dominan?
Sulit untuk menentukan siapa yang *sebenarnya* lebih dominan. Semut unggul dalam organisasi dan adaptasi sosial, sementara bakteri unggul dalam reproduksi cepat dan kemampuan beradaptasi dengan lingkungan ekstrem. Yang jelas, keduanya adalah kekuatan utama dalam dunia kehidupan.
Apakah Keseimbangan Populasi Ini Akan Terus Berlanjut?
Perubahan iklim, aktivitas manusia, dan faktor lainnya dapat mempengaruhi populasi semut dan bakteri. Penting bagi kita untuk memahami dampak tindakan kita terhadap keseimbangan ekosistem dan mengambil langkah-langkah untuk melestarikannya.


What's Your Reaction?
-
0
 Like
Like -
0
 Dislike
Dislike -
0
 Funny
Funny -
0
 Angry
Angry -
0
 Sad
Sad -
0
 Wow
Wow